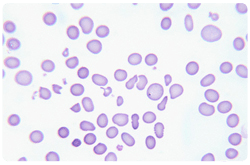
Anemia por deficiencia de vitamina B12

La vitamina B12 es la más grande (peso molecular 1355.4) y compleja de todas las vitaminas. Aunque el uso científico del término “vitamina B12” se restringe normalmente a la cianocobalamina, la vitamina B12 representa a todas las cobalaminas que son potencialmente biológicamente activas. Cobalamina es el término utilizado para referirse a un grupo de compuestos que contienen cobalto (corrinoides) que tienen un ligando axial inferior que contiene el nucleótido coordinado por cobalto (5,6-dimetilbencimidazol como base). Cianocobalamina, que se utiliza en la mayoría de los suplementos, se convierte fácilmente a las formas coenzima de la cobalamina (metilcobalamina y 5’-desoxiadenosilcobalamina) en el cuerpo humano.
La vitamina B12 es sintetizada solamente por ciertas bacterias y esta se concentra principalmente en los cuerpos de organismos predadores superiores en las cadenas alimenticias naturales. Los alimentos animales (carne, leche, huevo, pescados y mariscos) se consideran las principales fuentes dietarias de vitamina B12.
Algunos alimentos vegetales, como las algas comestibles o cianobacterias, contienen grandes cantidades de la vitamina, aunque los compuestos con actividad B12 en las algas parecen ser inactivos en los mamíferos.
Los alimentos contienen varios compuestos vitamina B12, con diferentes ligandos superiores. Metilcobalamina y 5’-desoxiadenosilcobalamina funcionan, respectivamente, como coenzimas de la enzima metionina-sintetasa, que participa en la biosíntesis de metionina, y de metilmolonil-CoA mutasa que está involucrada en el metabolismo de aminoácidos y de ácidos grasos de número impar en las células de mamíferos.
Los humanos poseen un proceso complejo para la absorción gastrointestinal de vitamina B12 dietaria. La vitamina liberada de la proteína en el alimento se une primero a haptocorrina (proteína en la saliva que se une a la vitamina B12) en el estómago. Luego de la proteólisis del complejo haptocorrina-vitamina B12 por proteasas pancreáticas en el duodeno, la vitamina B12 liberada se une al factor intrínseco (IF, por sus siglas en inglés, proteína gástrica que liga a vitamina B12) en el íleo proximal. El complejo IF-vitamina B12 puede entrar en las células mucosas del íleo distal mediante endocitosis mediada por receptor.
La biodisponibilidad de la vitamina B12 dietaria es significativamente dependiente de este sistema de absorción gastrointestinal. En los estándares de referencia para el consumo, se asume que la mitad de la vitamina B12 dietaria es absorbida en los adultos sanos; sin embargo, hay pocos datos sobre la biodisponibilidad de la vitamina B12 de los alimentos.
Requerimientos de vitamina B12 y deficiencia
Los principales signos de deficiencia de vitamina B12 son anemia megaloblástica y neuropatía. Los vegetarianos estrictos tienen un mayor riesgo de desarrollar deficiencia de vitamina B12 que los no vegetarianos y deben consumir alimentos fortificados con vitamina B12 o suplementos alimenticios que contengan la vitamina para prevenir dicha deficiencia.
Una alta proporción de personas ancianas con bajos niveles en suero de vitamina B12, sin anemia perniciosa, presentan malabsorción de vitamina B12 unida a proteína. La malabsorción de vitamina B12 unida al alimento se encuentra en pacientes con ciertas disfunciones gástricas, como gastritis atrófica con baja secreción de ácido en el estómago. Debido a que la biodisponibilidad de vitamina B12 cristalina no está alterada en los pacientes con gastritis atrófica, se recomienda que los adultos de 51 años de edad y mayores obtengan la mayoría de su vitamina B12 mediante el consumo de alimentos fortificados con vitamina B12 cristalina o suplementos que la contengan.
Hay reportes de que una dosis ligeramente mayor de suplementación de vitamina B12, de 50 µg/día, incrementa significativamente las concentraciones en suero de vitamina B12 en personas ancianas con estado anormal de la vitamina.
La recomendación dietaria diaria de vitamina B12 en adultos es de 2.4 µg/día; sin embargo, la pérdida corporal diaria de la vitamina se estima entre 2 µg/día y 5 µg/día, por lo que en general se recomienda un consumo diario de 6 µg/día para mantener una concentración estable de vitamina B12 así como de marcadores metabólicos relacionados a la vitamina B12.
Ensayo de vitamina B12 en alimentos
Históricamente el contenido de vitamina B12 en alimentos se ha determinado por bioensayo con ciertos microorganismos que requieren vitamina B12, como Lactobacillus delbrueckii subsp. Lactis ATCC7830 (previamente denominado Lactobacillus leichmannii).
El ensayo de dilución con radioisótopos (RIDA, por sus siglas en inglés) con vitamina B12 radiomarcada e IF de cerdo ha sido también empleada para la determinación del contenido de la vitamina en alimentos. Aunque se ha reportado que los valores determinados por el método RIDA son ligeramente más altos en suero humano que los determinados por el método microbiológico, se ha confirmado que hay una excelente correlación entre ambos métodos.
Un analizador de vitamina B12 por quimioluminiscencia totalmente automático con el derivado de vitamina B12 marcado con ester de acridinio existe en el mercado. Actualmente, varios tipos de analizadores similares están siendo utilizados en clínica e investigación para el ensayo rutinario de la vitamina B12 a nivel mundial, pero no se han podido aplicar en los análisis en alimentos, debido a que los valores determinados por el método microbiológico son varios órdenes de magnitud más altos que los determinados por el método de quimioluminiscencia. Esta diferencia puede deberse al hecho de que L. delbrueckii utiliza compuestos corrinoides que son inactivos para los humanos además de vitamina B12.
Vitamina B12 en los alimentos de origen animal
Carne
Se estima que el contenido de vitamina B12 en muestras cocidas de hígado de res, carne de res magra y en pavo es de 83, 3 y 33 µg/100 g, respectivamente, pues hay pérdidas apreciables (33% en promedio) de la vitamina durante la cocción.
La biodisponibilidad de vitamina B12 en 100 g (0.9 µg de vitamina), 200 g (3.0 µg) y 300 g (5.1 µg) de hamburguesas de cordero cocido, marcado con vitamina B12 radioactiva en individuos humanos normales es en promedio de 56%-77%, 76%-89% y 40%-63%, respectivamente. Una absorción promedio de vitamina B12 en paté de hígado (38 µg) es aproximadamente de 10%. Dado que el sistema de absorción intestinal mediado por IF se satura a 1.5-2.0 µg por comida bajo condiciones fisiológicas, la biodisponibilidad de vitamina B12 disminuye significativamente con incrementos en el consumo de la vitamina por comida.
La absorción de vitamina B12, valorada mediante la medición de excreción fecal de radioactividad luego de consumir 100 g (0.4-0.6 µg de vitamina), 200 g (0.8-1.3 µg) y 300 g (1.3-1.9 µg) de carne de pollo, marcada con vitamina radiactiva en sujetos humanos sanos promedia 65%, 63% y 61%, respectivamente.
Leche
Aunque el contenido de vitamina B12 (0.3-0.4 µg/100 g) de varios tipos de leche no es elevado, la leche y los productos lácteos contribuyen significativamente al consumo de vitamina B12, pues el consumo de lácteos es alto en la población en general. En la leche bovina, la vitamina B12 natural está ligada a transcobalamina, una de las proteínas unidas a vitamina B12 en los mamíferos.
Cuando vitamina B12 radiomarcada (0.25 µg) se mezcla con agua o leche y se administra a individuos humanos, la absorción media, valorada como cuenta corporal total de radioactividad es de 55% o 65%, respectivamente.
Se han reportado pérdidas apreciables de vitamina B12 durante el procesamiento de la leche. El hervir la leche por 2-5 minutos y por 30 minutos resulta en una pérdida de 30% y 50%, respectivamente. La cocción en microondas por 5 minutos deriva en una pérdida de 50%, mientras que la pasteurización provoca entre el 5% y el 10% de pérdida.
Las muestras de leche expuestas a luz fluorescente por 24 horas a 4°C, experimentan una disminución considerable en la concentración de vitamina B12, dependiendo del tipo de leche. Por otro lado, cuando leche pasteurizada se refrigera por 9 días bajo condiciones normales, no hay una disminución apreciable en la concentración de vitamina B12. Las concentraciones de vitamina B12 en las leches fermentadas disminuyen considerablemente durante el almacenamiento a 4°C por 14 días.
Aproximadamente 20%-60% de la vitamina B12 presente en la leche se recupera en el queso cottage, los quesos duros y los quesos azules. El contenido de la vitamina en el suero de leche se reduce durante la fermentación acidoláctica; esta disminución se debe a la producción de compuestos de vitamina B12 que no son fácilmente detectados por métodos convencionales de extracción.
Huevo
El contenido de vitamina B12 en el huevo entero es aproximadamente de 0.9 µg/100 g a 1.4 µg/100 g y la mayoría de la vitamina se encuentra en la yema. El consumo de vitamina B12 en el huevo es generalmente alto, al ser un alimento muy popular.
La biodisponibilidad de vitamina B12 de las yemas de huevo revueltas, huevos enteros revueltos, huevos cocidos y huevos fritos (1.1 a 1.4 µg de vitamina B12 por 100 g) es en promedio de 8.2%, 3.7%, 8.9% y 9.2%, respectivamente. La vitamina B12 en el huevo es generalmente absorbida de manera pobre, en comparación a otros alimentos animales.
Pescados y mariscos
Los mariscos que se alimentan mediante sifón de microorganismos sintetizadores marinos, son excelentes fuentes de vitamina B12, en concentraciones que pueden llegar a exceder los 10 µg/100 g.
Los microorganismos que sintetizan vitamina B12 pueden también sintetizar varios corrinoides (incluyendo compuestos corrinoides inactivos para los humanos) con diferentes bases en el ligando menor.
Cuando los compuestos corrinoides son aislados y caracterizados en ostiones, mejillones y almejas de cuello corto, todos los compuestos corrinoides son identificados como vitamina B12, lo que los identifica indudablemente como fuentes de la vitamina.
El contenido de vitamina B12 en algunos peces, como salmón, sardina, trucha y atún de aleta azul está entre 3.0 y 8.9 µg/100 g. El músculo obscuro del bonito contiene una cantidad substancial de vitamina (159 µg/100 g) cuando se compara con el musculo claro (porción dorsal 10 µg/100 g, porción ventral 8 µg/100 g), con resultados similares en el atún aleta amarilla.
Varios caldos para sopa, comercialmente disponibles, hechos principalmente con restos de bonito seco o sardinas secas, contienen considerable cantidad de vitamina B12 (0.2-1.2 µg/100 g) indicando que son buenas fuentes de esta.
La pérdida de vitamina B12 en la carne de pescado por varios métodos de cocción (hervido, vaporizado, salteado, freído y microondas) no es elevado, con un rango de 2.3% a 14.8%.
Pescado salteado y fermentado
La mayor cantidad de vitamina B12 descrita en un alimento está en el riñón de salmón salteado y fermentado, conocido como “Mefun”, con 328 µg/100 g. Una sola porción de 0.8 g de Mefun proporciona el consumo recomendado diario para la población adulta.
Aunque tiene un sabor delicado, su aplicación es extremadamente limitada, por lo que se popular solamente en Japón.
La vitamina B12 que se encuentra en Mefun no se deriva de bacterias sintetizadoras de vitamina B12, sino que está acumulada en el riñón del salmón. La mayoría de la vitamina recuperada se encuentra en las fracciones de vitamina B12> libre.
El Mefun puede ser una excelente fuente de vitamina B12 para personas ancianas con malabsorción de vitamina B12 ligada al alimento.
Salsa de pescado
Existen varios tipos de salsa de pescado que se emplean como suplemento y como sazonador. La salsa de pescado (Nam-pla, en Thai) parece constituir una de las fuentes principales de vitamina B12 en algunos países como Tailandia.
La salsa de pescado tradicional japonesa “Ishiru” posee también una cantidad considerable de la vitamina (2.3 µg/100 g – 5.5 µg/100 g). Los compuestos corrinoides encontrados en varias salsas de pescado en Japón no han podido ser identificados.
Dado el bajo nivel de consumo en las poblaciones occidentales y en algunas poblaciones orientales, sumado a la falta de identificación de los compuestos corrinoides, la salsa de pescado no puede considerarse como una fuente de vitamina B12.
Vitamina B12 en los alimentos de origen vegetal
Verduras
Por décadas, se ha creído que los brotes comestibles de bambú contenían cantidades considerables de vitamina B12; sin embargo, no es así, aunque se encontraron ciertos compuestos que muestran actividad de vitamina B12, conocidos como factor resistente al álcali.
Resultados similares se han encontrado en lotes de col, espinaca, apio, crisantemo, bulbo de lila y taro. Cantidades traza de vitamina B12> (<0.1 µg/100 g), que no incluyen el factor resistente al álcali, en brócoli, espárrago, germinado de frijol y otros, que se cree obtuvieron de los fertilizantes orgánicos empleados en el cultivo de estos lotes específicos.
La adición de un fertilizante orgánico como el estiércol, incrementa significativamente el contenido de vitamina B12 en los cultivos como cebada y espinaca. De manera similar, en los cultivos hidropónicos, el remojar las semillas en una solución rica en vitamina B12 o incorporar la vitamina en el fertilizante permite la incorporación de la misma en los brotes y frutos, con registros en algunos casos de cerca de 170 µg/100 g.
Hojas y bebidas de té
Varios tipos de hojas de té poseen cantidades considerables de vitamina B12, como las hojas de té verde (0.1-0.5 µg/100 g peso seco), azul (0.5 µg/100 g), rojo (0.7 µg/100 g) y negro (0.3-1.2 µg/100 g).
El té negro fermentado japonés (Batabata-cha, en japonés) contiene un compuesto corrinoide identificado como vitamina B12, que es biodisponible para ratas y para humanos. No obstante, se requieren varios litros de consumo diario de bebida fermentada de té (más que los 1-2 litros consumidores regularmente en Japón) para cubrir la recomendación diaria de consumo de la vitamina B12 en los adultos.
Soya
Los niveles de vitamina B12 en el frijol de soya son bajos o indetectables. Una bebida fermentada de soya, el tempe, contiene una gran cantidad de vitamina B12 (0.7 µg/100 g a 8 µg/100 g), lo que se cree puede deberse a contaminación bacteriana durante el proceso de producción del tempe.
Otra bebida fermentada de soya, el natto, contiene cantidades diminutas de vitamina B12(0.1 µg/100 g a 1.5 µg/100 g).
Algas comestibles
Varios tipos de algas comestibles se emplean en el consumo humano a nivel mundial. Las hojas (nori) secas de alga verde (Enteromorpha sp) y púrpura (Porphyra sp) están entre las mayormente consumidas y contienen cantidades substanciales de vitamina B12 (32 µg/100 g a 78 µg/100 g peso seco).
En la cocina japonesa, varias hojas de nori (9×3 cm, unos 0.3 g cada una) son con frecuencia servidas en el desayuno. En otras poblaciones, grandes cantidades de nori se consumen (< 6 g) en ciertos sushi.
No obstante, fuera de estas dos especies, otras algas comestibles contienen solamente trazas de vitamina B12.
La biodisponibilidad de vitamina B12 de algas en humanos no está clara, pero se sabe que es biodisponibles en ratas, al menos en Porphyra yezoensis.
Los estudios a la fecha sugieren que el consumo de nori puede ayudar a los vegetarianos estrictos a evitar la deficiencia de vitamina B12, particularmente cuando se incluye en la dieta también la microalga Chlorella sp.
Cianobacterias comestibles
Algunas especies de cianobacterias, incluyendo Spirulina spp, Aphanizomenon spp y Nostoc spp, se producen a tasas anales de 500 a 3000 toneladas tanto para alimento como para la industria farmacéutica. Las tabletas que contienen Spirulina sp. se venden como producto saludable de moda, por las cantidades de vitamina B12 que contienen (127 µg/100 g a 244 µg/100 g), siendo los dos compuestos corrinoides principales pseudovitamina B12 (83%) y vitamina B12 (17%).
No obstante, los estudios indican que la pseudovitamina B12 es difícilmente absorbida en el intestino mamífero, por lo que aparentemente no está biodisponible para los humanos.
La cianobacteria de agua dulce Aphanizomenon flos-aquae, natural de Norteamérica, contiene algunos corrinoides identificados como pseudovitamina B12. Aphanothece sacrum, cianobacteria comestible originaria de Japón y que se comercializa con el argumento de su alto contenido de vitamina B12, solo contiene pseudovitamina B12 por lo que su valor nutritivo es cuestionable. Nostoc commune contiene cantidad considerable de vitamina B12, pero solo el 12% de esta es activa en humanos.
Al contener grandes cantidades de pseudovitamina B12, las cianobacterias comestibles no pueden recomendarse como una fuente de vitamina B12, que prevenga la deficiencia en la población en riesgo, como vegetarianos estrictos y ancianos.
Cereales fortificados
Los cereales para desayuno, listos para comer, fortificados con vitamina B12 contribuyen con una parte importante de la vitamina en la dieta de varios países occidentales, incluyendo los Estados Unidos.
La fortificación incluye normalmente ácido fólico, vitamina B12 y vitamina B6, con la finalidad de incrementar la concentración en sangre de estas vitaminas y disminuir la concentración total de homocisteina en plasma en la población de edad avanzada.
Estos cereales constituyen una fuente valiosa de vitamina B12 para ancianos y vegetarianos.
La dificultad para valorar el contenido de vitamina B12 o corrinoides inactivos en ciertos alimentos puede resolverse mediante el empleo de una técnica simple, bioautografía con Escherichia coli dependiente de vitamina B12, luego de la separación de la muestra por cromatografía en capa delgada de gel de sílice 60.
Es un hecho que la base de datos con el contenido de vitamina B12 en los alimentos debe ser revisada luego de una precisa valoración del contenido real de vitamina B12.
De forma similar, al confirmar la biodisponibilidad real de vitamina B12 en los alimentos, se deberá ajustar las recomendaciones diarias de consumo.
En relación a las fuentes dietarias de vitamina B12, que dependerán en buena medida de las culturas y hábitos locales, se observa lo siguiente:
• Los alimentos de origen animal como carnes, lácteos, huevo, pescados y mariscos son excelentes fuentes y deben ser las preferidas.
• Las cianobacterias comestibles, empleadas como suplementos alimenticios no son buenas fuentes de vitamina B12, debido a su alto contenido de pseudovitamina B12, que no es biodisponible para los humanos.
• Es factible que la investigación y desarrollo de productos alimenticios de origen vegetal con cantidades considerables de vitamina B12, fortificados con vitamina B12 cristalina, pueda contribuir a mantener niveles adecuados en la población en general y a prevenir la deficiencia entre los segmentos en riesgo.



Muchas gracias por la información.
Sobre el consumo de spirulina…
¿la pseudo vit. b12 impide que podamos recibir la verdadera vit. b12?
¿que hay de los otros aportes de la spirulina, teniendolos en cuenta, recomendaria consumirla?
Hola Simona,
Gracias por tu interesante pregunta.
Para contestarla te platico brevemente cómo se absorbe la vitamiba B12. Un porcentaje mínimo (menor al 1%) se absorbe por difusión pasiva a través de la mucosa intestinal. Casi toda la vitamina B12 consumida por vía oral requiere que esté unida a una proteína ligadora en el lumen intestinal, conocida como ‘factor intrínseco’, que es una glicoproteína secretada por la mucosa gástrica. Recuerda que la vitamina en el alimento está unida a proteínas, no está libre, así que es necesario que el ácido gástrico y la pepsina degraden las proteínas a que está unida la vitamina B12 para liberarla. Ya libre y todavía en el estómago, la vitamina B12 se une a la cobalofilina, que es una proteína secretada en la saliva y unida a ella es que pasa al duodeno, en donde los jugos pancreáticos liberan nuevamente a la vitamina B12 de la cobalofilina y entonces puede unirse al factor intrínseco, para poder ser absorbida a través de la mucosa intestinal, que es en el tercio distal del íleon, a través de las células mucosas con sitios especiales en los cuales se une el factor intrínseco UNIDO a la vitamina B12).
Bueno, la clave está en que el factor intrínseco sólamente se une a la forma biológicamente actva de la vitamina B12, no a los análogos como la pseudovitamina B12, y además hay un enorme exceso de factor intrínseco disponible, así que creo que sería poco probable que el consumir Spirulina pudiera afectar la absorción de vitamina B12, siempre y cuando la dieta incluya la vitamina B12 como tal.
Hay estudios que confirman que la Spirulina tiene efectos hipolipidémicos, antioxidantes y antiinflamatorios, además de que tiene proteínas de alto valor biológico que incluye los aminoácidos esenciales (aunque algunos en cantidades mínimas) y una buena variedad de ácidos grasos, incluso omegas 3 y 6.
No veo razón para no consumir la Spirulina, siempre y cuando sean un complemento a la dieta variada y no un substituto y especialmente el que si se consume como comprimidos o en polvo (las dos formas más comunmente comercializadas) se tenga la certeza de que el fabricante/envasador sea lo suficientemente serio como para garantizar que el producto está libre de contaminantes (determinado por el sitio de origen del alga y por el procedimiento de procesamiento y empacado). Recuerda además que el término Spirulna se refiere solamente al género de esta cianobacteria, que incluye muchas especies, y no todas las especies tienen la misma composición.
Finalmente, recuerda que en cuanto a la vitamina B12, no importa la cantidad que consumas, solamente se absorberá entre 1.0 y 1.5 microgramos por cada dosis oral, que es lo que el cuerpo humano requiere. Asegúrate de incluir alimentos de origen animal (carne de rumiantes terrestres así como pescados y mariscos, lácteos y huevo) en tu dieta y si lo deseas, substituye parte de las proteínas con la Spirulina (confirmando que sea un producto de origen seguro).
Espero que la información te sea de utilidad.
Saludos.
wao!! vaya que me ha sido de grandisima ayuda…
mucho bien, gracias!